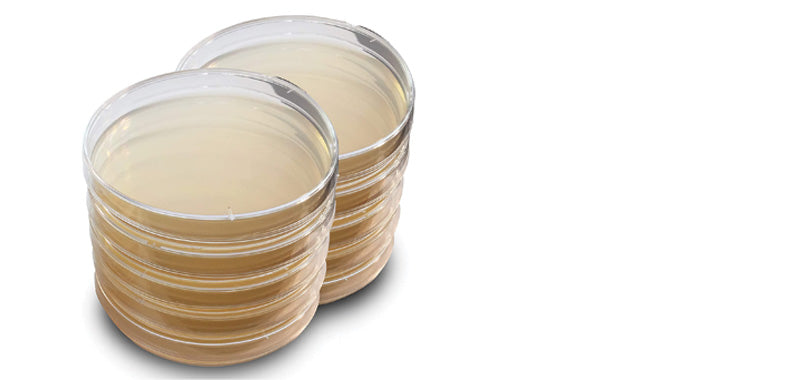
Agar, Bacto
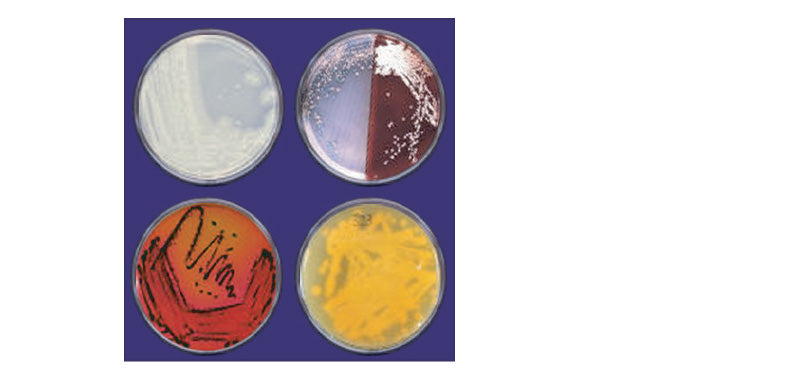
Agar, Bacto

GenDEPOT | SKU:
A2007-050
13% off
Agar, Bacto
$191.00
$219.00
Unit price
/
Unavailable
Shipping calculated at checkout.
Care information
Care information
Display general product information or specific product information using metafields.
Delivery and Shipping
Delivery and Shipping
Add some general information about your delivery and shipping policies.
Payment & Security
Payment methods
Your payment information is processed securely. We do not store credit card details nor have access to your credit card information.